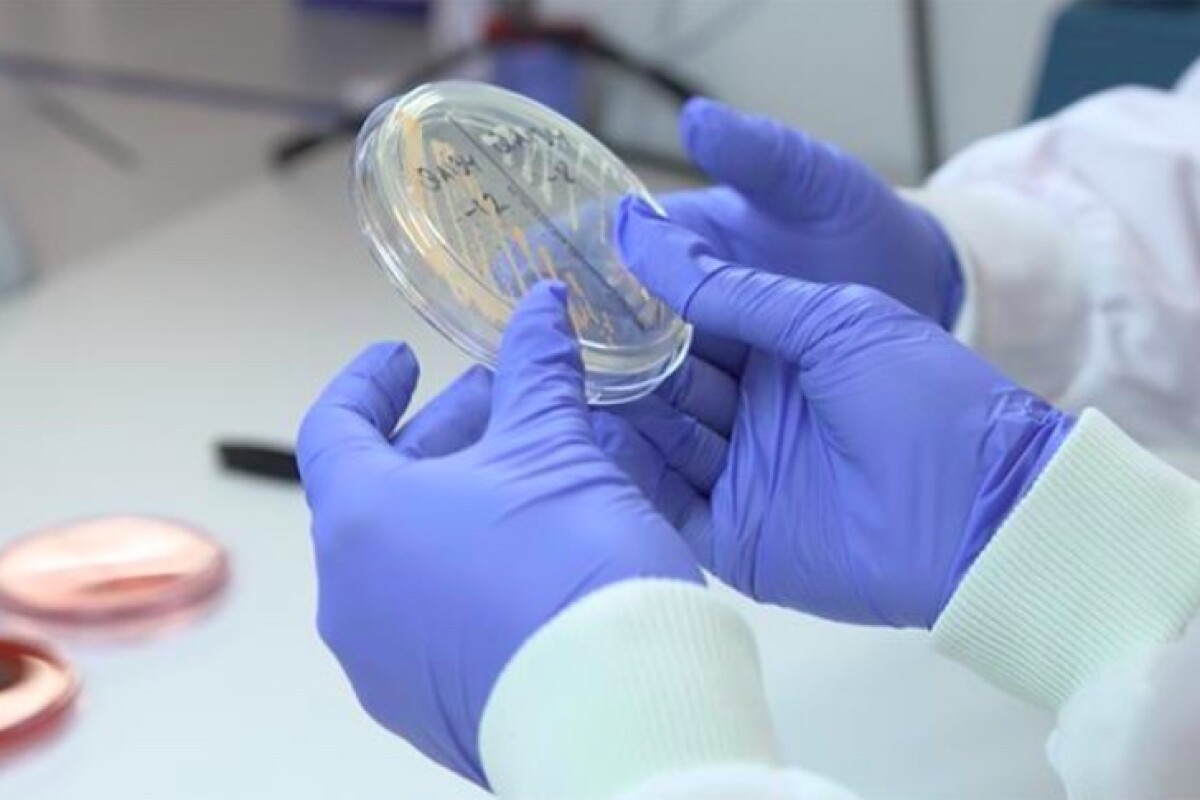

Fibrant incorporates an advanced moisture management system to keep you cool dry and odor free. Whereas Fine Guard Gloves are comfortable reusable and use the patented and certified LIVINGUARD Technology to kill 9999 of viruses.
 Leave Fresh Feeling And Pleasant Scent Kill Germs And Viruses Antibacterial Disinfection Girl Rubber Gloves Cleaning Stock Image Image Of Clean Help 203634163
Leave Fresh Feeling And Pleasant Scent Kill Germs And Viruses Antibacterial Disinfection Girl Rubber Gloves Cleaning Stock Image Image Of Clean Help 203634163
Use hot washes but not always the hottest.

Gloves that kill germs. Ordinary disposable gloves are not only uncomfortable but can pick up germs and viruses just by coming in contact with any infected surface. Ad British made hand hygiene training lotion. The Gloves are designed so they are comfortable to wear all day.
We so often hear horror stories of hospital-acquired bugs such as MRSA or Cdifficile that gloves. The doctor then scribbles on the blue glove with a pen in order to show how germs can attach to the material. Abena Antimicrobial Gloves do just this.
Use regular spot cleaner or color-safe bleach and a brush if needed to remove stains before you put them in the washer. Clinell CDS60-1 Universal Spray Surface Cleaning and Disinfectant Spray Antimicrobial Kills 9999 Percent of Germs Effective from 30 Seconds 60 ml bottle. While conventional medical gloves serve only as a passive barrier between microbes and your hands Abena Antimicrobial Gloves have a built-in antimicrobial technology that actively helps to reduce the risk of cross-contamination and thus spread of infections.
You keep touching more things throughout the. Ad The Top Womens Apparel to Your Door. Carell Bed Bath Gloves - Easy to use Containing Aloe Vera Dermatologically Tested Alcohol-Free - Pack of 8 Gloves.
How to kill germs when washing clothes. Please always take the correct precautions. Despite the little thats known about the virus there are still a number of measures which can be taken to kill germs.
The answer to contamination risks food hygiene and operator hand protection this unique detectable vinyl glove is the ultimate in food safety handling. GermBana Gloves are made from Fibrant the revolutionary fabric infused with a natural agent that kills germs on contact including MRSA. Copper gloves are the best option its speculated by many professionals that they kill germs on contact and some claim to see no traces of bacteria.
Were fighting a pandemic and if left unwashed dirty hands that slip into gloves can be housing a party of bacteria inside. Like most patients you probably think the sight of a medic wearing latex gloves is a good thing. There you go germs.
45 out of 5 stars 50. Treat suede gloves with protective suede spray before you wear them. Copper gloves are the best option its speculated by many professionals that they kill germs on contact and some claim to see no traces of bacteria after 30 minutes.
You wouldnt be able to touch anything or anyone else without the risk of passing on that infection. Air-dry them though to prevent them from shrinking. The only gloves proven to kill Covid 19 on contact.
Hypoallergenic and safe for sensitive skin. Detect-a-glove vinyl is detectable in the electromagnetic range 50Khz-1Mhz ensuring that a small torn piece will not contaminate or end up in the product bought by the consumer. Free UK Delivery on Eligible Orders Today.
When it comes to accumulating germs polyester gloves are the worst culprit followed by fleece leather and wool. Importantly on everyday items such as clothes towels sportswear and more. But being hygienic has never been more important than ever before.
You can wash cotton gloves in the washing machine in cold water. Vegan friendly and safe for all skin types. How can I help stop the spread.
If you want to wear gloves the most effective way to prevent germs from spreading would be to bring hand sanitizer with you and dispose of the gloves as soon as you step out of the store. By purchasing a pair of copper gloves your actually doing more than just protecting yourself.
 Person In Gloves Disinfecting Light Switch Panel Surface With Disinfectant Spray To Kill Germs Bacteria And Virus Banque D Images Et Photos Libres De Droits Image 146437928
Person In Gloves Disinfecting Light Switch Panel Surface With Disinfectant Spray To Kill Germs Bacteria And Virus Banque D Images Et Photos Libres De Droits Image 146437928
 World S First Antibacterial Glove Helps Stop Infections Medical Plastics News
World S First Antibacterial Glove Helps Stop Infections Medical Plastics News
Does Alcohol Kill Germs Yes As Long As The Solution Is Strong Enough
 Buy Just Peachy Germ Prevention Protection Kit 3 Ply Face Masks 3 Hand Sanitizer 3 Gloves 1 Hand Wash Online At Low Prices In India Amazon In
Buy Just Peachy Germ Prevention Protection Kit 3 Ply Face Masks 3 Hand Sanitizer 3 Gloves 1 Hand Wash Online At Low Prices In India Amazon In
A Hand In A Blue Protective Latex Glove Holds Garlic To Help Kill Germs Modern Trend Hole In Paper With Copy Space Coronavirus Treatment Concept Stock Images Page Everypixel
 Person In Gloves Disinfecting Table Surface With Disinfectant Spray To Kill Germs Bacteria And Virus Stock Photo Alamy
Person In Gloves Disinfecting Table Surface With Disinfectant Spray To Kill Germs Bacteria And Virus Stock Photo Alamy
 Amg Antimicrobial Glove Kills Up To 99 999 Microbes Hartalega Youtube
Amg Antimicrobial Glove Kills Up To 99 999 Microbes Hartalega Youtube
 Kill Germs And Viruses Antibacterial Disinfection Girl Rubber Gloves Cleaning Hold Plastic Bottle Chemical Liquid Product Canstock
Kill Germs And Viruses Antibacterial Disinfection Girl Rubber Gloves Cleaning Hold Plastic Bottle Chemical Liquid Product Canstock
How To Kill Germs Everything You Need To Know
 Virus Preventing Workout Gloves Copper Infused Compression Gloves
Virus Preventing Workout Gloves Copper Infused Compression Gloves
New Medical Gloves Use Microorganism Killing Molecule To Eradicate Bacteria
New Medical Gloves Use Microorganism Killing Molecule To Eradicate Bacteria
 Effective Cleaning Image Photo Free Trial Bigstock
Effective Cleaning Image Photo Free Trial Bigstock


No comments:
Post a Comment
Note: Only a member of this blog may post a comment.